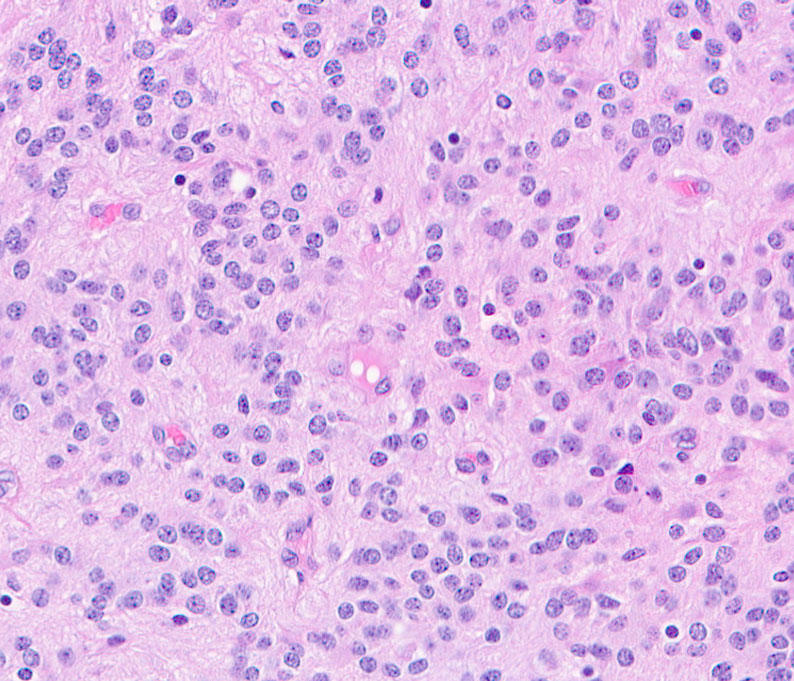
Microscopy image of tumor tissue

Classifying Brain and Spine Tumors More Precisely to Improve Patient Outcomes and Care
, by Kendall Morgan, NCI-CONNECT Contributor
Neuropathologist Dr. P.J. Cimino shares how he collaborates with NCI-CONNECT experts to improve diagnosis and care for people with rare brain and spine tumors.
When people with central nervous system (CNS) tumors visit the NCI-CONNECT Clinic at NIH, they learn their precise tumor type and if they have a molecular marker that could impact treatment or tumor growth. This knowledge comes from a neuropathologist—a specialized doctor whom patients may never encounter during clinic visits.
Meet neuropathologist P.J. Cimino, M.D., Ph.D., head of the NIH National Institute of Neurological Disorders and Stroke’s Surgical Neurology Branch (SNB) Neuropathology Unit. Dr. Cimino works with the NCI-CONNECT Clinic, which is overseen by the NCI Center for Cancer Research’s Neuro-Oncology Branch (NOB). He is dedicated to improving the lives of patients with rare CNS cancers by examining their tumor tissue in novel ways. His expertise also includes reviewing medical records, diagnoses, and test results to ensure that every new visitor to the NCI-CONNECT Clinic gets the best care possible.
“As a pathologist, I’m used to being behind the scenes,” Dr. Cimino says. “I’m one of the doctors that the patients never meet. I went to medical school, but now my patient interaction comes through more interdisciplinary interaction with other providers.”
A More Precise Diagnosis to Guide Care
Rare tumors are often difficult to diagnose because many doctors may have never seen them before. That’s where Dr. Cimino’s expertise is essential.
“Even if you had surgery and pathology done somewhere else, it’s important for us to review the samples, records, and diagnosis,” Dr. Cimino explains. “Within our neuropathology team, we’re all experts in the classification of brain and spinal cord tumors."
In addition to reviewing patients’ information, Dr. Cimino and the neuropathology team also perform additional molecular testing on the tumor tissue, including methylation testing.
Methylation refers to patterns of chemical methyl marks on the DNA within cancer cells. In addition to changes in the DNA or genes, these patterns can change the way a cancer will grow—which affects how doctors will treat it. These marks are sometimes likened to volume knobs. They can turn the activity of genes up or down in ways that influence the speed of a cancer’s growth or spread. Importantly, each type of tumor has a unique set of marks—similar to a “methylation fingerprint”—that can come in handy when some tumors look alike under the microscope.
The NOB is one of only a few places in the world where patients can access methylation testing for rare CNS tumors in the clinic. “We use these methylation patterns and other test results to more accurately classify the tumor, especially if it wasn’t completely profiled before,” Dr. Cimino says. “We will either confirm the diagnosis or, in some cases, we will refine or even change the diagnosis to reflect the latest World Health Organization classifications.”
As a pathologist, I’m used to being behind the scenes—I’m one of the doctors that the patients never meet.
Dr. Cimino’s influence doesn’t end with the test results or a diagnosis on paper, however. Each week, he participates in the NOB’s Neuro-Oncology Tumor Board with other experts both inside and outside NIH. Tumor boards are regular meetings in which a group of doctors and other health care providers from different specialties come together to discuss cancer cases and provide recommendations.
“I’m part of the clinical team that talks through the diagnosis and precise classification of a patient’s tumor, and then decides what treatment or care might be most appropriate,” Dr. Cimino says. “It is a critical step to ensure the best possible outcome for every patient that goes to the NCI-CONNECT Clinic.”
A ‘Bench-to-Bedside’ Approach to Improving Glioblastoma Care
Dr. Cimino doesn’t only rely on existing studies and techniques to classify CNS tumors. He and his Neuropathology Unit also spearhead research to better understand what drives CNS cancers and how to classify them more precisely, in hopes of improving treatment and patient outcomes.
“We’re working with patient tumor tissue samples to define biomarkers that can be used to help predict a person’s prognosis or likely outcome,” Dr. Cimino says. “It’s a ‘bench-to-bedside’ approach. Some of the data coming out of our studies is collected from patients who are seen in the Neuro-Oncology Branch.”
Much of Dr. Cimino’s research is focused on using molecular or genetic testing to accurately diagnose and treat glioblastoma, the most common brain cancer in adults. For example, one of his studies helped to explain why a duplication of chromosome 7 fuels glioblastoma growth. Chromosomes are bundles of tightly coiled DNA found inside most cells. Healthy human cells should have 23 pairs of chromosomes, so having extra pairs can wreak havoc with vital cellular processes. Dr. Cimino’s work helped to identify some of the genes on chromosome 7 that may explain why cancer cells with this chromosomal duplication survive and grow to produce a more aggressive tumor that may require aggressive treatment.
Dr. Cimino has also explored the big picture implications of such fundamental molecular differences among glioblastoma cases. His findings have shown that including molecular profiling when enrolling patients in trials is key. This step can help to ensure that patients with various tumor subtypes are clearly represented in clinical trials. It can also help doctors understand how clinical trial results may apply to their patient’s specific subtype of CNS cancer.
A Tissue Bank for Future Research and Discovery
As head of the SNB’s Neuropathology Unit, Dr. Cimino is instrumental in ensuring that other NIH investigators—including those in the NOB—will have access to the tissue samples they may need to make critical discoveries. The Neuropathology Unit also collects and maintains neurosurgical tissue for the SNB’s biorepository. This tissue is available for SNB investigators and is also accessible for collaborative research across the NIH.
“We collect, store, and bank all the research specimen tissues coming out of neurosurgical operations at NIH,” Dr. Cimino says. “With a patient’s consent, we get frozen tissue for use in research when our neurosurgeons operate.”
Dr. Cimino’s efforts ensure that tissue that might otherwise be discarded instead fuels future discoveries—which could help to better classify rare CNS cancers and find new ways to treat them. It’s yet another way that Dr. Cimino’s expertise, experience, and efforts contribute to a better future for all people with rare CNS cancers.